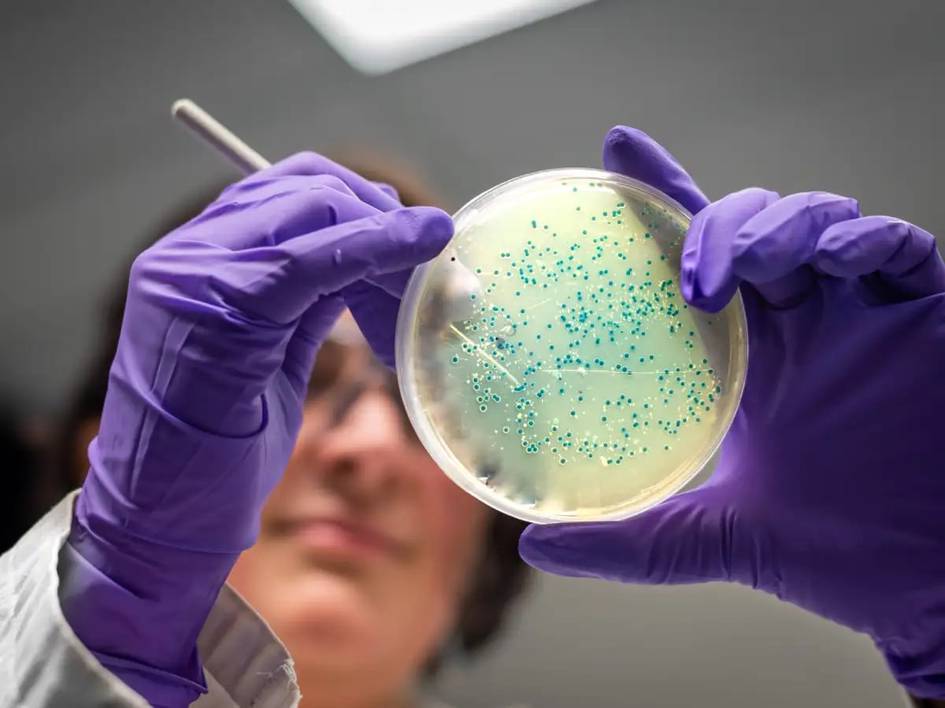
Антибиотикларга чидамлилик сабаб 2050 йилгача 40 млн киши ўлиши мумкин

Қидирув натижаси "касаллик"

АҚШ Эбола эпидемияси зонасида бўлган грин-карта эгаларининг мамлакатга киришини тақиқлади

Бир ҳафталик очлик организмни қандай ўзгартириши олимларни ҳайратга солди

Организм қаришини секинлаштириш учун қанча ухлаш кераклиги аниқланди

“Эбола дастлабки тахминлардан кўра тезроқ тарқалмоқда” — ЖССТ

ЖССТ Эбола эпидемиясини глобал фавқулодда ҳолат деб эълон қилди

Саёҳатда ҳантавирус юқтириб олишга сабаб бўладиган 10 та ҳолат

Ҳафтасига камида 5 та тухум ейиш Альцгеймер хавфини камайтиради — тадқиқот

Конгода Эбола эпидемияси авж олди: 65 киши вафот этди

Нима учун узоқ вақт ўтирганда бел оғрийди?

Испания ва Атлантикадаги олис оролда ҳам ҳантавирус аниқланди

Круиз кемасида хавфли вирус тарқалди, уч киши ҳалок бўлди

Биргина машқ тури 8 та касаллик хавфини кескин камайтириши аниқланди: тадқиқот натижалари ҳайратланарли

Ҳеч нарса безовта қилмаса ҳам онколог кўригидан қачон ўтиш керак?
.jpg)
Рациондан чиқариб ташланг: қандли диабет хавфини оширадиган тўрт хил одатий озиқ-овқат

Бангладешда қизамиқ эпидемиясидан 194 нафар бола вафот этди

Олимлар ёшликда орттирилган ортиқча вазн ўлим хавфини оширишини исботлади
Антибиотикларга чидамлилик сабаб 2050 йилгача 40 млн киши ўлиши мумкин

74 ёшли туркиялик хонанда Иброҳим Татлисас шошилинч равишда касалхонага ётқизилди

Бангладешда касалликдан 100 га яқин бола вафот этди

Кимёвий идиш ювиш воситалари организмни зарарлаши қанчалик ҳақиқат?

“Nipah вирусининг Ўзбекистонда тарқалиш эҳтимоли жуда паст” — Нурмат Отабеков

Ғазодаги уруш туфайли Исроил ҳарбийлари орасида руҳий касаллар кўпайди

“Ўзбекистонда Nipah вируси қайд этилмади” — Санэпидқўмита

Халқаро ёрдам қисқариши оқибатида 2025-йилда беш ёшгача бўлган 4,8 миллион бола вафот этди

Ҳиндистон пойтахтида ифлос ҳаво сабаб 3 йилда 200 мингта ўткир респиратор касаллик қайд этилди

Семизлик Альцгеймер ривожланишини тезлаштириши мумкин – тадқиқот

Кубада чивинлар юқтирадиган касалликлардан 33 киши вафот этди
Кўпроқ янгиликларни юклаш